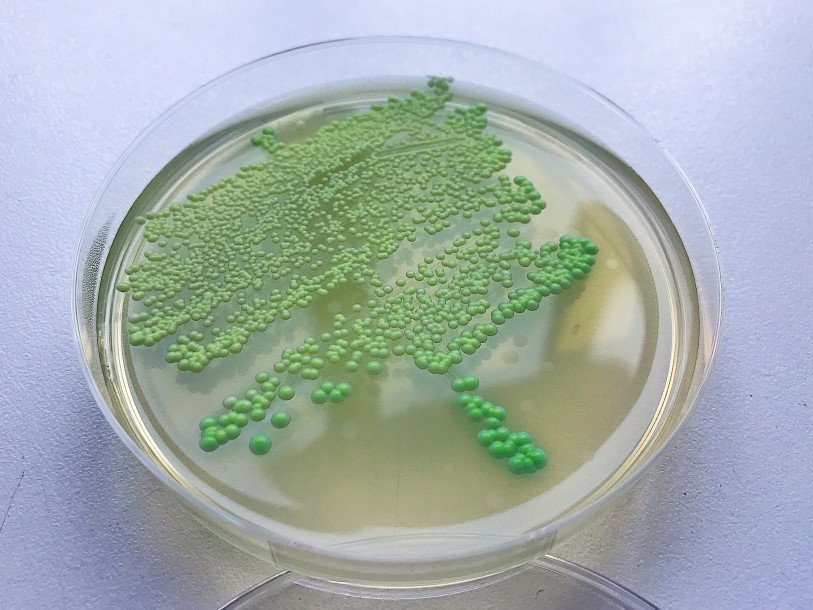

Екатерина Беленко: Промикробы: Грибы большие и маленькие
Candida albicans Екатерина Беленко Вполне логичным кажется тот факт, что объект интереса бактериолога — это бактерии. Так-то оно так, да не совсем. Среди тех милых малышей, которые вырастают на наших чашках Петри, встречаются, например, ещё и грибы. Чем не микроб, если растёт на питательной среде и размером соответствует? А строением всего своего одноклеточного организма. Дело в том, что бактерии относятся к прокариотам, а грибы, хоть даже и микроскопические, — к эукариотам. Прокариоты не имеют оформленного клеточного ядра и других мембранных органоидов, таких как митохондрии и эндоплазматический ретикулум. Соответственно, у эукариот всё это богатство есть. Эукариоты бывают одноклеточными и многоклеточными, тогда как прокариоты — только одноклеточные. Да, бактерии могут объединяться, но в таких объединениях они остаются отдельными личностями.
⠀
Попробуйте теперь угадать — кого на планете больше? Напомню, что за команду «Прокариоты» играют бактерии, а за «Эукариот» — все остальные организмы, от грибов рода Кандида (на фото) до слона и борщевика. С точки зрения биомассы и количества видов, прокариоты являются наиболее представительной формой жизни на Земле. Например, прокариоты в море составляют 90 % от общего веса всех организмов, а в одном грамме плодородной почвы более 10 миллиардов бактериальных клеток. Впечатляет, да?
Но вернёмся к нашему сегодняшнему герою-грибу. Это Candida albicans, что плохо стыкуется с внешними данными, ведь означает «белый», прямо как альбинос и Джессика Альба. На простых питательных средах колонии действительно белые, а вы видите посев на хромогенную среду. Спасибо прогрессу в области изготовления питательных сред за то, что можно любоваться таким зелёным красавчиком. На этом агаре разные виды грибов рода Кандида окрашиваются в разные цвета. Не все, конечно, ведь видов этих много, но самые часто встречающиеся возбудители. Кандиду можно и по запаху отличить — приятный дрожжевой аромат то ли пива, то ли сдобы. Очень возбуждает аппетит, особенно до обеденного перерыва. Поэтому, вспоминая строчки из классика, тем, кто ложится спать, — спокойного сна, а тем, кто садится есть, — приятного аппетита.
Смотрите также: Екатерина Беленко Промикробы: моча, окутанная мифами Екатерина Беленко Промикробы: Загадочный дисбактериоз Екатерина Беленко Промикробы: Знакомьтесь, синегнойная палочка! Екатерина Беленко Среда для микробиологов Новое Татьяна Пигарева Испания от И до Я Сергей Сергеев Русское самовластие. Власть и ее границы: 1462–1917 гг. Катерина Михалева-Эгер 350 лет современной моды Леонид Чутко Сил нет Катя Колпинец Формула грез Сергей Плохий Забытые бастарды Восточного фронта Дэвид Чиверс, Том Чиверс Цифры врут. Как не дать статистике обмануть себя Пол Стейнхардт Невозможность второго рода Стивен Хоффман Пять сил, изменяющих все Уолтер Айзексон Взломавшая код Рустам Александер Закрытые. Жизнь гомосексуалов в СССР 3D-каркасы для восстановления костной ткани Платиновый бутерброд для спинтроники